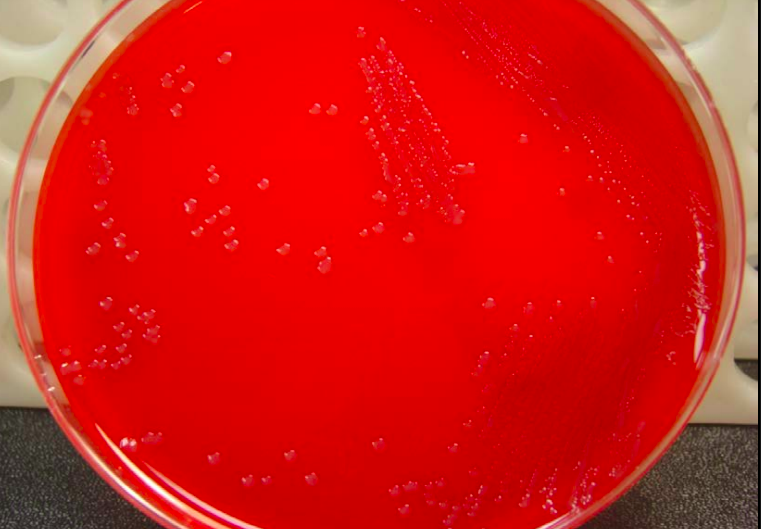
Neisseria meningitidis in Blood Agar - Neisseria meningitidisin Blood Agar

Neisseria meningitidis (Nm), also referred to as meningococci are fastidious, aerobic Gram-negative diplococci with adjacent sides flattened (lens-shape/half-moon-shaped). It is a commensal of the nasopharynx for about 10% of immunocompetent individuals.
Meningococci cause sepsis and life-threatening meningitis commonly referred to as invasive meningococcal disease (IMD) in susceptible individuals. Each year, approximately 1.2 million IMD cases have been reported worldwide, with the African meningitis beltreporting the highest incidence.

Meningococcal-meningitis incidence rates are generally highest in children under five, followed by adolescents. IMD’s case fatality rate (CFR) ranges from 4.1% to 20%.

General Properties of Neisseria meningitidis
- Gram-negative intra-cellular diplococci
- Neisseria meningitidis (meningococcus) has a prominent polysaccharide capsule that enhances virulence through its complement inhibitory and antiphagocytic action. Nonencapsulated N. meningitidis isolates are generally considered nonpathogenic. The capsule is also the immunogen in the meningococcal vaccine.
- **Serogroups:**Based on the antigenic nature of capsular polysaccharides, N. meningitidis can be typed into 13 serogroups (A-D, X-Z, 29E, W135, H-J, and L). Six serogroups (types) of Neisseria meningitidis A, B, C, W, X, and Y cause the majority of cases of IMDs worldwide.

Serotype A was the leading cause of epidemic meningitis worldwide, mainly in the African meningitis belt. However, its incidence decreased after the introduction of group A meningococcal polysaccharide–tetanus toxoid conjugate vaccine (PsA-TT; MenAfriVac) in Africa in 2010.
Pathogenesis
Transmission
Neisseria meningitidislives as normal upper respiratory tract flora in young adults. Carriage is highest in adolescents and young adults (approx 10%), mostly due to their lifestyle. Carriage rates are generally lower in older adults and infants.
The bacteria are transmitted from person to person through carriers’ droplets of respiratory or throat secretions. Smoking, close and prolonged contact (such as kissing, sneezing, or coughing), or living in close quarters with a carrier facilitates the spread of the disease. The reasons for transitioning from asymptomatic carriage to invasive disease are not completely understood.
Virulence factors
Several virulence factors such as capsule, lipooligosaccharides, fimbriae, IgA1 protease, Por A, Por B proteins, etc. contribute to the pathogenesis of N.meningitidis. Find details here: Virulence factors produced by Neisseria meningitidis and their roles in pathogenesis
Once a new susceptible individual is colonized, the organisms may sometimes breach the nasopharyngeal mucosal barrier and enter the bloodstream to cause invasive disease.
Clinical Manifestations
The two main clinical manifestations of invasive meningococcal disease are meningitis (75% – 80%) and septicemia (15% – 20%). Occasionally, meningococci cause other infections, including pneumonia, pericarditis, conjunctivitis, endophthalmitis, septic arthritis, pelvic disease, or chronic low-grade septicemia.
Meningococcal meningitis
Meningococcal meningitis is a serious infection of the meninges that affects the brain membrane. The liberation of endotoxin (by the bacteria) into the subarachnoid space provokes a marked cytokine-mediated inflammation of the meninges. Early symptoms are fever, malaise, nausea, shivers, tachycardia, and mild headache. As the illness progresses, headache may become more pronounced, accompanied by photophobia, confusion, and vomiting (due to raised intracranial pressure), followed by coma if untreated. In newborns and babies, symptoms such as being slow or inactive, irritable, vomiting, feeding poorly, or the presence of a bulging in the soft spot of the skull (anterior fontanelle) may be an indication rather than the classic symptoms.
Septicemia
A less common but even more severe (often fatal) form of meningococcal disease is meningococcal septicemia, characterized by a hemorrhagic rash and rapid circulatory collapse. Most patients become progressively ill within 24 to 48 hours. However, in a few cases, the disease progresses so rapidly that the patient becomes moribund or dies within a few hours of the onset of infection.
Laboratory Diagnosis
Sample
Cerebrospinal fluid (CSF), blood and skin scrapings from petechial rashes from cases, and nasopharyngeal swabs from carriers. Specimens should be collected in sterile containers and transported immediately without any delay.
CSF shouldnever be refrigeratedas suspected agents of meningitis (pneumococci, meningococci, andHaemophilus influenzae) are delicate and may die on refrigeration).
Gram Stain
In Gram-stained smear of centrifuged deposit of specimen (CSF or sterile body fluid), N. meningitidisappear as Gram-negative, coffee-bean-shaped diplococci occurring intracellularly or extracellularly in PMN leukocytes.
Culture
Isolation of N. meningitidis(from blood, CSF, or other normally sterile sites) remains the gold standard as it also provides isolates for strain differentiation and susceptibility testing.
Since meningococci are fastidious, samples from sterile body sites are inoculated on either blood or chocolate agar. The chocolate agar base can be enriched with antibiotics such as vancomycin, colistin, nystatin, and trimethoprim for selective isolation of N. meningitidis. For culture from non-sterile sites such as the nasopharynx, a selective media such as Modified New York City or Modified Thayer Martin medium are required. Culture plates should be incubated for a minimum of 48 hours with a source of 5% CO2.
On Blood agar, young colonies of N. meningitidis are round, smooth, moist, glistening, and convex, with a clearly defined edge whereas actively growing colonies are grey and unpigmented. Older cultures (> 24 hours) become more opaquely grey and sometimes cause the underlying agar to turn dark.
On Modified New York City medium and Thayer Martin medium, Neisseria meningitidisappears as large colorless to bluish-gray mucoid colonies.
Identification
Biochemical tests for the Identification of Nesisseria meningitidis:
- Catalase Positive
- Oxidase positive.
- Produce acid from glucose and maltose but not from lactose or sucrose.
- Nitrate Reduction Test: negative
- Produce gamma-glutamyl aminopeptidase
- Resistant to colistin: meningococci are colistin-resistant and grow on selective media containing VCN inhibitor
- DNAse reaction: negative
- Superoxol Test (reaction with 30% hydrogen peroxide): may show weak to a strong reaction.
- Pigmentation: produce pink-brown pigments.
Serogrouping
Various serogroups of N.meningitidis are differentiated by slide agglutination test using monovalent antisera.
Serological tests
Several serological tests, such as enzyme immunoassay, latex agglutination, and rapid diagnostic tests, are available to detect antibodies against capsular antigens of Neisseria meningitidis. Serological tests help in the retrospective diagnosis of disease. Antibodies are also seen when vaccination is successful and in cases of chronic meningococcemia.
Molecular diagnosis
PCR-based diagnosis provides confirmation of meningococcal disease from blood, CSF, or other normally sterile sites with a validity comparable to that of culture-based diagnosis.
References and Further Readings
- Nadine G. Rouphael N G and Stephens D S “Neisseria meningitidis: Biology, Microbiology, and Epidemiology” Methods Mol Biol. 2012; 799: 1–20.
- Keith A.V. Cartwright “Neisseria meningitidis”
- WHO manual “Laboratory Methods For diagnosis of Meningitis caused by N.meningitidis, S.pneumoniae and Haemophilus influenzae, 2nd edition. WHO_IVB_11.09_eng.pdf